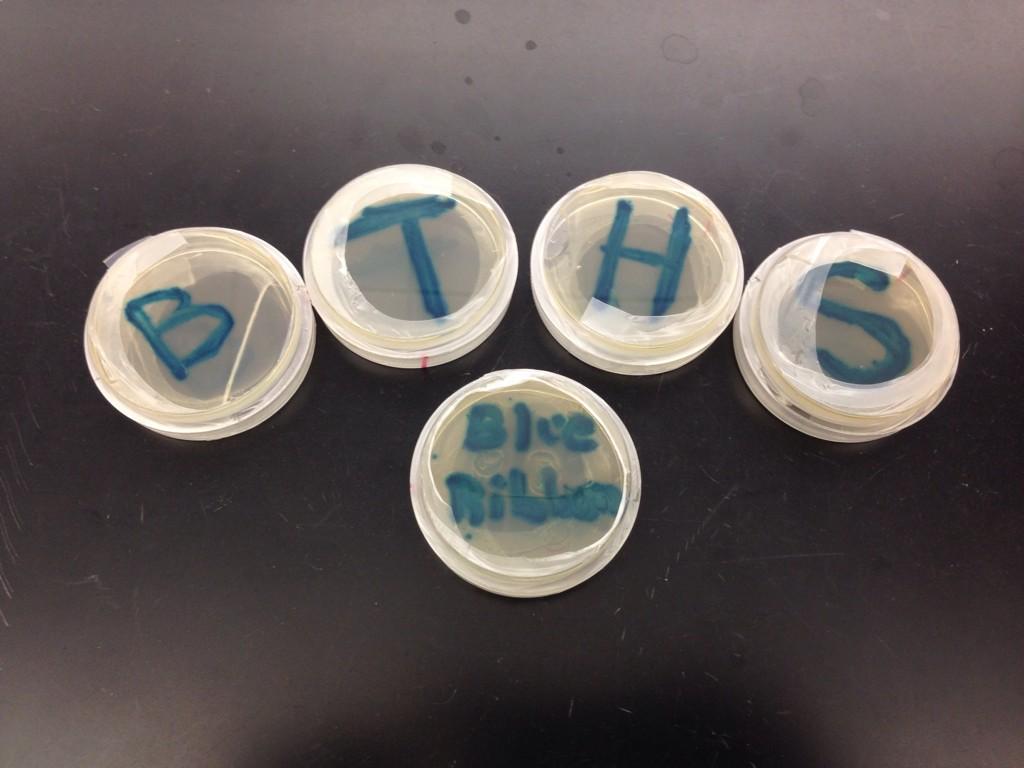
David Fusco tweet media

@united Day 6 and my father is still without luggage. He returns in two days. Deeply disappointed with United!!!
English
David Fusco
31 posts


@dfusk
Science and Math Supervisor @ Freehold Township HS; Former STEM Supervisor @ Red Bank Regional HS; Former Biotechnology Teacher @biotechnologyhs